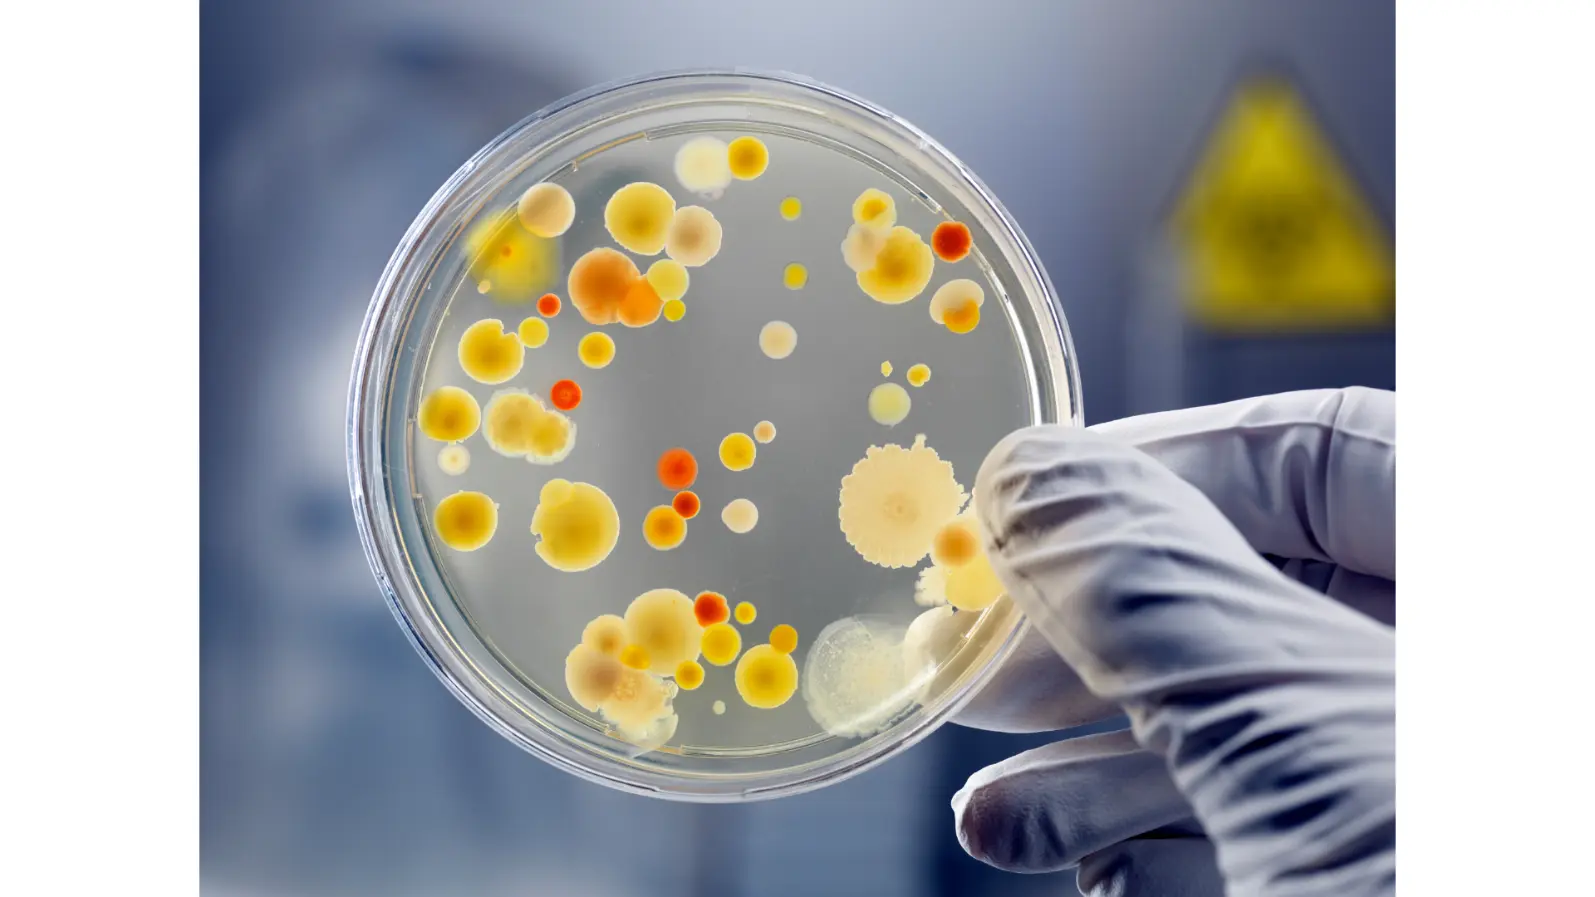

From Forest to City: How Nepal’s Changing Lifestyles Shape the Bacteria in Our Mouths
A Journey Through Nepal’s Lifestyles
For centuries, Nepal has been home to communities with vastly different lifestyles from jungle foragers in remote hills to farmers in the fertile plains and urban migrants abroad. A study published in Microbiome (2024) by Erica P. Ryu and colleagues explores how these diverse ways of living influence one of the most personal ecosystems of all: the oral microbiome, the community of bacteria and other microbes that live in our mouths.
While scientists have long known that lifestyle affects the gut microbiome, much less is known about its effect on the mouth. The oral microbiome plays key roles in digestion, immunity, and dental health, yet its global diversity and its response to modernization has rarely been studied.
Why Nepal Is the Perfect Case Study
To untangle lifestyle from geography (a common problem in microbiome studies), the researchers focused on five Nepali groups spanning a spectrum of lifestyles:
Chepang – traditional foragers living in remote Himalayan hills
Raji and Raute – formerly nomadic groups who only began farming within the past 50 years
Tharu and Newar – long-established agricultural communities
Newar expats in the U.S. – migrants adapting to industrial life abroad
Plus a small comparison group of American industrialists
By studying people from a single country but with very different daily habits, the team could isolate lifestyle effects from geography or genetics.
What the Researchers Found
Microbial diversity stayed stable but composition changed.
When geography was controlled, the number of microbial species in saliva didn’t differ much among Nepali groups. However, the types of bacteria shifted gradually along the lifestyle gradient from traditional to industrialized forming a clear pattern.
Some bacteria faded with industrialization.
Species such as Streptobacillus and members of the Porphyromonadaceae family were more common in traditional communities but decreased in more modern ones. These microbes may represent part of the “vanishing microbiome” linked to the rise of lifestyle-related diseases.
Others thrived in modern mouths.
The genus Atopobium, often associated with dental caries and other oral diseases, increased in industrialized groups hinting that modernization might favor bacteria linked to poorer oral health.
Lifestyle habits mattered.
Dietary staples (like grain type), smoking, and even consumption of sisnu (stinging nettle) showed measurable associations with certain oral bacteria. For instance, people who ate barley and maize had more of the genus Brachymonas compared with rice- or wheat-based diets.
Beyond the Mouth: A Glimpse of the Gut Connection
Interestingly, individuals’ mouth and gut microbiomes became slightly more similar as lifestyles grew more agrarian, suggesting a subtle link between oral and intestinal ecosystems a connection that may influence overall health.
Why It Matters
This study is one of the first to chart a continuous lifestyle gradient from foraging to industrialization within a single cultural context. Its findings suggest that modernization doesn’t simply reduce microbial diversity; it reshapes the community structure in complex ways.
Understanding these shifts could help scientists better grasp how changes in diet, environment, and habits affect oral and systemic health worldwide.
Key Takeaway
Lifestyle not just where we live plays a vital role in shaping our microbial companions. As the world continues to urbanize, preserving microbial diversity in our mouths might be just as important as protecting biodiversity in nature.
Reference:
Ryu, E. P., Gautam, Y., Proctor, D. M., et al. (2024). Nepali oral microbiomes reflect a gradient of lifestyles from traditional to industrialized. Microbiome, 12:228.